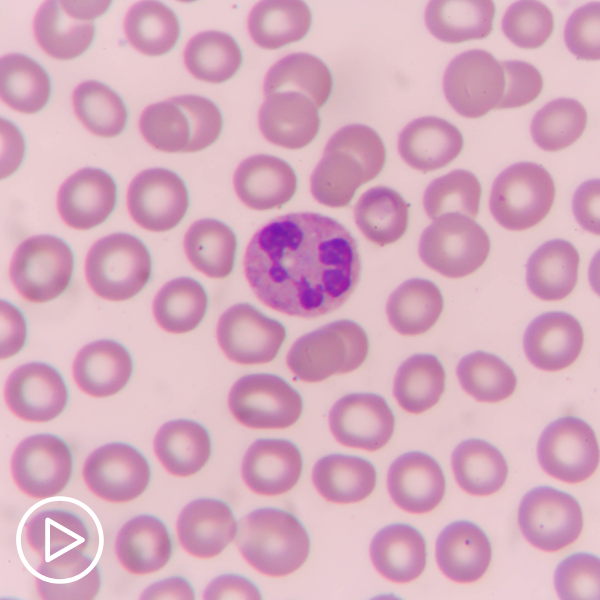

New Developments in MPN Care

https://vimeo.com/702232474 Does myeloproliferative neoplasm (MPN) care have new developments? Dr. Kristen Pettit from Rogel Cancer Center shares MPN research updates she hopes to hear about at ASCO 2022. See More From the…
Are Mobile-Optimized Tools Impacting MPN Care?

https://vimeo.com/702232326 How is myeloproliferative neoplasm (MPN) impacted by mobile-optimized tools? Dr. Kristen Pettit from Rogel Cancer Center shares digital education resources and patient education websites to aid in MPN patient support and…
Why Is Specialized Care Important for MPN Patients?

https://vimeo.com/702232281 Specialized myeloproliferative neoplasm (MPN) care is an option for many patients. Dr. Kristen Pettit from Rogel Cancer Center explains various ways that specialized MPN care can benefit patients and MPN conditions…
Should MPN Patients and Their Families Continue Telemedicine?

https://vimeo.com/702232167 Can myeloproliferative neoplasm (MPN) patients still get value from telemedicine? Dr. Kristen Pettit from Rogel Cancer Center explains some of the pros and cons of telemedicine visits and ways to optimize…
What Is Chronic Neutrophilic Leukemia?
https://vimeo.com/702231970 Chronic neutrophilic leukemia (CNL) is a rare form of myeloproliferative neoplasm (MPN). Dr. Kristen Pettit from Rogel Cancer Center explains mutations involved in CNL and common CNL symptoms. See More From…
Notable New MPN Treatments

https://vimeo.com/702231939 What’s the latest in myeloproliferative neoplasm (MPN) treatments? Dr. Kristen Pettit from Rogel Cancer Center gives updates about treatment developments for myelofibrosis, polycythemia vera (PV), and essential thrombocythemia (ET) care including…
What Is Next Generation Sequencing for MPNs?

https://vimeo.com/702231899 Myeloproliferative neoplasm (MPN) care may include the use of next generation sequencing. Dr. Kristen Pettit from Rogel Cancer Center explains next generation sequencing and how it is used in MPN patient…
What Is Precision Medicine for MPNs?

https://vimeo.com/702231633 Myeloproliferative neoplasm (MPN) patients have the option of precision medicine in the treatment toolbox. Dr. Kristen Pettit from Rogel Cancer Center shares insight about some forms of precision medicine, disease-specific factors,…
MPN Treatment Tools and Advancements

https://vimeo.com/702231602 Dr. Kristen Pettit from Rogel Cancer Center shares MPN treatment updates and recent approvals for patient care. See More From the MPN TelemEDucation Related Resources What Do Biosensors Mean for…
What Do Biosensors Mean for Myeloproliferative Care?

https://vimeo.com/702236133 Myeloproliferative neoplasm (MPN) patients can benefit from recent advances in medical uses of biosensors. Watch to learn about biosensor medical advances, advantages for MPN care, and future developments from…
What Does Teleoncology Mean for Myeloproliferative Care?

https://vimeo.com/702236070 Myeloproliferative neoplasm (MPN) patients can benefit from various aspects of teleoncology. Watch to learn about teleoncology, benefits for MPN patients, and potential future developments with teleoncology. See More From…
What Is the Role of Next-Generation Sequencing in MPNs

https://vimeo.com/703422718 Myeloproliferative neoplasm (MPN) patients can take advantage of a medical advancement called next-generation sequencing. Watch to learn about next-generation sequencing, what it means for MPN patient care, and potential…